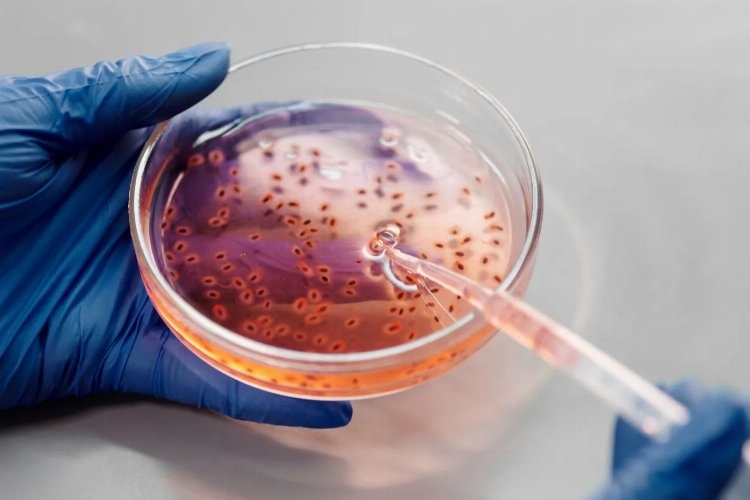
İnsan Vücudunun En Kirli Yeri galerisi resim 2

İnsan Vücudunun En Kirli Yeri
07 Ocak 2023 Cumartesi 20:42İnsan Vücudunun En Kirli Parçası Düzenli olarak duş alarak vücudumuzu mikroplardan, bakterilerden ve mikroplardan temizleyebiliriz, ancak yine de vücudun kolayca erişilemeyen bir kısmı vardır. Burası deniz göbeği, göbek düğmesi olarak da bilinir ve sadece duş alarak temizlenemez. Burası zengin bakteri kaynağı ve vücudumuzun en kirli kısmı. Göbeğin düşmüş şekli, tüm kir, ter, ölü cilt hücreleri, giysi lifleri, sabun ve losyonları toplamasını mümkün kılar. Yıkamak çok zordur ve dediğimiz gibi, mikroorganizmayı geliştirmek için mükemmel bir ortamdır. Bu size ve sağlığınıza çok zararsız olabilir, çünkü enfeksiyona neden olabilir ve hoş olmayan bir kokusu olabilir. İki tür göbek vardır, drenajlı ve çıkıntılı. Bir araştırmaya göre göbeğinizin doğal olarak ısınması durumunda, iyi hijyen sağlamanıza ve düzenli duş almanıza rağmen 65-70 farklı bakteri türünün toplanmaya yatkın olduğunu göstermiştir.
Haberimizin devamını okumak için Lütfen sonraki sayfaya geçiniz...
Haber Yazılımı: So Bilişim